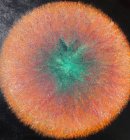
Supernova

Paintings
A selection of my paintings.
All are painted in oil on canvas.

All are painted in oil on canvas.


Reaching Out

Invisible Birds

Drifters

No Ordinary Day 1

No Ordinary Day 2

Cornish Beach
Supernova

Union Jack Kaleidoscope

Dry dock, Penzance

Bristol Coloured Houses

Red Flag Godrevy

St Ives Cornwall

Undisturbed

Star Surfer

All at Sea

Cardiff Waterfront.

Tornado!

Autumn Lane

7 Station Avenue

Bristol from Toghill.

Chesil Dawn.

Glastonbury Tor

Cornish Kites

Dartmoor Stones

First Light

Helvellyn Storm.

The Kids at Padstow

Landcombe Cove

Martial of the Falls 2

Dartmoor Stream

Natural Born Killers

Sailing past Old Harry Rocks

Portrait of an Old Man

Portrait of an Old Woman

The Brecons

Forgotten Corner

St Michaels Mount

Windsurfers in Blue

Big Wave Surfer

War Window

Cornish Sunset

 Instagram
Instagram